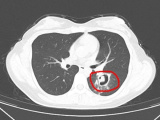

-
 Người đẹp Myanmar đăng quang Hoa hậu Văn hóa Thế giới 2026, đại diện Việt Nam giành Á hậu 2
Người đẹp Myanmar đăng quang Hoa hậu Văn hóa Thế giới 2026, đại diện Việt Nam giành Á hậu 2 -
 Choáng ngợp cơ ngơi 4 tầng nam nghệ sĩ đình đám dành tặng vợ trẻ kém 37 tuổi sau khi sinh quý tử
Choáng ngợp cơ ngơi 4 tầng nam nghệ sĩ đình đám dành tặng vợ trẻ kém 37 tuổi sau khi sinh quý tử -
 Người lao động thu nhập dưới 15,5 triệu đồng/tháng được miễn thuế thu nhập cá nhân từ 1/7
Người lao động thu nhập dưới 15,5 triệu đồng/tháng được miễn thuế thu nhập cá nhân từ 1/7 -
 Động thái kỳ lạ của ca sĩ Tim sau khi mặc áo Ronaldo, dùng áo Messi để rửa xe rồi ném xuống đất
Động thái kỳ lạ của ca sĩ Tim sau khi mặc áo Ronaldo, dùng áo Messi để rửa xe rồi ném xuống đất -
 Mỹ nhân Việt sở hữu visual "mặt trời theo chân", được khen đẹp chấn động khi đụng hàng sao Hoa ngữ
Mỹ nhân Việt sở hữu visual "mặt trời theo chân", được khen đẹp chấn động khi đụng hàng sao Hoa ngữ -
 Người dân có thể trực tiếp khám phá Quy hoạch tổng thể Thủ đô Hà Nội tầm nhìn 100 năm từ chiều 29/6
Người dân có thể trực tiếp khám phá Quy hoạch tổng thể Thủ đô Hà Nội tầm nhìn 100 năm từ chiều 29/6 -
 Sự thật ngỡ ngàng: Travis Kelce từng không định nghiêm túc khi tiếp cận Taylor Swift?
Sự thật ngỡ ngàng: Travis Kelce từng không định nghiêm túc khi tiếp cận Taylor Swift? -
 Phương Oanh khiến hơn 22 nghìn khán giả xôn xao khi tìm lại "tình yêu"
Phương Oanh khiến hơn 22 nghìn khán giả xôn xao khi tìm lại "tình yêu" -
 Nỗi đau tột cùng của người cha mất 3 đứa con trong 3 năm vì đuối nước
Nỗi đau tột cùng của người cha mất 3 đứa con trong 3 năm vì đuối nước -
 Khoảnh khắc rực sáng phút bù giờ đưa Canada vào tứ kết World Cup
Khoảnh khắc rực sáng phút bù giờ đưa Canada vào tứ kết World Cup
Đời sống
06/04/2026 14:51Thử lại quần jeans cũ khi dọn tủ, người đàn ông phải cấp cứu
Theo trang QQ, sự việc xảy ra với anh Trần (32 tuổi, Trung Quốc) khi đang dọn dẹp tủ quần áo tại nhà. Trong lúc sắp xếp đồ đạc, anh tìm thấy một chiếc quần jeans đã mặc nhiều năm trước và quyết định thử lại để kiểm tra độ vừa vặn.
Ngay sau khi mặc chiếc quần vào, anh Trần bất ngờ cảm thấy hơi nhói và khó chịu ở đùi phải. Nhận thấy dấu hiệu bất thường, anh nhanh chóng cởi quần ra và lắc. Một con nhện rơi xuống sàn rồi bò đi. Kiểm tra lại, anh phát hiện hai vết chấm nhỏ ở mặt trong đùi.
Do không nhìn rõ con nhện và cho rằng vết cắn không nghiêm trọng, anh chỉ bôi thuốc rồi tiếp tục dọn dẹp. Tuy nhiên đến tối cùng ngày, anh bắt đầu sốt cao, đồng thời xuất hiện các đốm đỏ tại vùng da bị cắn.

Theo lời khuyên của gia đình, anh đến bệnh viện địa phương để điều trị. Dù thân nhiệt sau đó đã trở lại bình thường, tình trạng vết thương không cải thiện. Hai ngày sau, các nốt phát ban lan ra tay chân, vùng bụng và mắt cá chân cũng xuất hiện dấu hiệu đỏ.
Trước diễn biến bất thường, bệnh viện địa phương chuyển bệnh nhân đến khoa da liễu của bệnh viện tuyến trên. Khi tiếp nhận, bác sĩ ghi nhận vùng đùi trong bên phải xuất hiện các mảng đỏ, bầm tím và nhiều bọng nước lớn.
Sau khi thăm khám, nhóm bác sĩ chẩn đoán bệnh nhân bị hoại tử mô cục bộ và nhiễm độc toàn thân do nọc độc nhện gây ra. Người bệnh sau đó được chuyển vào phòng điều trị để giải độc và theo dõi.
Chia sẻ về sự việc, anh Trần cho biết bản thân đã chủ quan. “Tôi đã quá bất cẩn, lơ là cảnh giác vì đang ở nhà. Tôi không ngờ vết cắn của nhện lại độc đến vậy. Tôi đáng lẽ phải đến bệnh viện ngay lập tức, nếu không vết thương nhỏ này có thể dẫn đến nhiễm độc toàn thân”, anh nói.
Theo các chuyên gia, nhện thường không chủ động tấn công con người nhưng có thể cắn khi bị quấy rầy hoặc trong mùa sinh sản. Vì vậy, người dân được khuyến cáo kiểm tra quần áo, giày dép trước khi mặc, đặc biệt với đồ đã để lâu trong tủ hoặc khu vực ít sử dụng.
Ngoài ra, cần giữ nhà cửa khô ráo, thường xuyên dọn dẹp các góc khuất, loại bỏ mạng nhện quanh cửa sổ và cửa ra vào. Với những nhà gần khu vực nhiều cây cối hoặc cỏ rậm, việc lắp lưới chắn côn trùng cũng được khuyến nghị.
Khi tham gia hoạt động ngoài trời, người dân nên hạn chế ngồi lâu trên bãi cỏ, khe đá hoặc đống lá rụng. Nếu di chuyển vào khu vực hoang dã, nên mặc quần áo dài tay, quần dài và buộc gọn ống quần để giảm nguy cơ bị côn trùng cắn.








- Trụ sở Ủy ban châu Âu dậy sóng vì lệnh tắt điều hòa giữa mùa hè lịch sử (38 phút trước)
- Đắk Lắk: Mẹ kêu con trai dừng xe rồi đột ngột gieo mình xuống sông, người thân hé lộ nguyên nhân (39 phút trước)
- Những kỹ năng "vàng" giúp tài xế làm chủ tay lái khi ô tô bị trượt bánh trên đường mưa (49 phút trước)
- Ronaldinho trở lại sân cỏ ở tuổi 46 (1 giờ trước)
- Vụ bé gái bị sát hại, phi tang ở Đắk Lắk: Đánh nạn nhân bất tỉnh rồi ném xuống giếng để cướp xe điện (1 giờ trước)
- Apple tìm cách mua RAM từ doanh nghiệp Trung Quốc trong "danh sách đen" của Mỹ (1 giờ trước)
- 6 loại cây cảnh được cho là cản trở tài lộc, chuyên gia phong thủy khuyên chỉ nên trồng ngoài sân (1 giờ trước)
- Người đẹp Myanmar đăng quang Hoa hậu Văn hóa Thế giới 2026, đại diện Việt Nam giành Á hậu 2 (1 giờ trước)
- Đường dây làm giả gần 20.000 phiếu thử nghiệm lĩnh án: Hợp thức hóa hàng trăm hồ sơ chứng nhận hợp quy (1 giờ trước)
- Choáng ngợp cơ ngơi 4 tầng nam nghệ sĩ đình đám dành tặng vợ trẻ kém 37 tuổi sau khi sinh quý tử (1 giờ trước)
Bài đọc nhiều